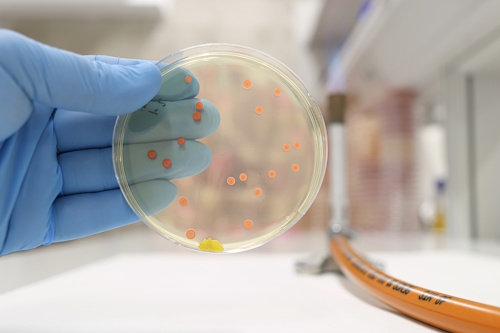
Диагностика энтероколита Диагностика энтероколита

Энтероколит

Энтероколит — это воспалительное заболевание кишечника, при котором поражаются одновременно слизистые оболочки тонкого и толстого кишечника. Процесс сопровождается нарушением всасывания, изменением моторики, появлением диареи, болей в животе и общей слабости. В зависимости от характера течения различают острый энтероколит, возникающий внезапно и часто связанный с инфекцией, и хронический энтероколит, который развивается постепенно и может быть связан с длительными нарушениями пищеварения, аутоиммунными процессами или последствиями перенесенных заболеваний кишечника.
История заболевания
Энтероколит известен с древних времен: упоминания о кишечных расстройствах встречаются в работах Гиппократа и Авицины, где описывались диарея, боли в животе и общая слабость при воспалительных процессах кишечника. В XIX веке немецкий врач Фридрих Август фон Бисмарк впервые выделил понятие «энтероколит» как отдельную нозологическую единицу, описав изменения слизистой как отличительные признаки болезни. В XX веке с развитием микробиологии и эпидемиологии были установлены конкретные инфекционные возбудители, вызывающие острый энтероколит, а также связь хронических форм с аутоиммунными процессами и нарушениями обмена веществ.
Современные исследования показали, что энтероколит кишечника может развиваться не только из-за инфекций, но и под влиянием неправильного питания, стрессов, лекарственной терапии или нарушений иммунного ответа. На сегодняшний день заболевание изучается комплексно, с акцентом на профилактику осложнений, раннюю диагностику и индивидуальный подход к лечению.
Классификация
Для определения стратегии терапии и прогнозирования течения заболевания выделяют несколько типов энтероколита.
По характеру течения:
- Острый энтероколит — внезапное начало, интенсивные боли, диарея, возможна интоксикация.
- Хронический энтероколит — медленно развивающееся воспаление, сопровождающееся периодическими рецидивами и длительным нарушением функций кишечника.
По этиологии:
- Инфекционный энтероколит — вызван бактериями, вирусами или паразитами.
- Воспалительный энтероколит — связан с аутоиммунными нарушениями, хроническими воспалительными процессами кишечника.
- Некротический энтероколит — тяжелая форма, при которой происходят очаговые некрозы слизистой, чаще встречается у недоношенных детей и новорожденных с ослабленным иммунитетом.
По локализации поражения:
- Преимущественно тонкокишечный — воспаление ограничено тонкой кишкой.
- Преимущественно толстокишечный — воспаление распространяется на толстую кишку.
- Смешанный — одновременно поражены оба отдела кишечника.
Выделение типа и формы энтероколита позволяет врачу выбрать адекватную лечебную тактику, корректировать питание, назначать необходимые обследования и предотвращать осложнения.
Симптомы
Энтероколит характеризуется рядом клинических проявлений. В зависимости от формы заболевания, интенсивность симптомов может быть разной. Общие признаки заболевания: боль в животе, чаще схваткообразная или тупая, локализующаяся в области пупка или по всей брюшной полости, частые кишечные расстройства — диарея с слизью или примесью крови, метеоризм и вздутие; снижение аппетита, общая слабость и утомляемость.
При остром энтероколите наблюдаются внезапное повышение температуры, интенсивные боли, водянистый или пенистый стул, иногда тошнота и рвота. Хроническая форма чаще сопровождается умеренными болями, периодическими диареями, чередованием запоров и поносов, снижением массы тела и нарушением усвоения питательных веществ.
Особенность инфекционного энтероколита — быстрый рост симптомов после контакта с патогеном. Хронический воспалительный процесс проявляется медленно, но постепенно нарушает нормальное функционирование кишечника и может привести к дефициту витаминов и микроэлементов.
Причины
Основные факторы развития энтероколита различны в зависимости от формы заболевания.
Инфекционные причины: бактерии (сальмонелла, эшерихия коли, шигелла), вирусы (ротавирус, норовирус) и паразиты (лямблии, амебы) вызывают острый энтероколит. Патогенные микроорганизмы повреждают слизистую кишечника, провоцируют воспаление и усиливают моторную активность, что проявляется диареей.
Неинфекционные причины включают: нарушения микрофлоры кишечника, аллергические реакции, длительный стресс, лекарственные препараты (антибиотики, нестероидные противовоспалительные средства) и хронические болезни ЖКТ, такие как язвенный колит или болезнь Крона.
Пищевые факторы: употребление продуктов с высоким содержанием консервантов, острых и жирных блюд, а также недостаток клетчатки может способствовать развитию воспаления.
Таким образом, энтероколит развивается под влиянием комплекса факторов, включающих инфекционные, иммунные и пищевые причины.
Особенности энтероколита у разных возрастных групп
Энтероколит у взрослых
У взрослых энтероколит часто развивается после пищевых отравлений или вирусных инфекций. Симптомы выражены умеренно или ярко — боли в животе, диарея, иногда слабость и субфебрильная температура. Хронические формы возникают при длительных нарушениях питания, стрессах или хронических воспалительных процессах кишечника.
Энтероколит у детей
У детей заболевание протекает более остро. Инфекция быстро распространяется, вызывая диарею, рвоту, боли в животе и обезвоживание. Патология может привести к нарушению роста и развития, особенно при частых рецидивах. В младшем возрасте энтероколит кишечника симптомы проявляются бурно, и требуется тщательное наблюдение.
Энтероколит у новорожденных
У новорожденных часто диагностируется некротический энтероколит — тяжелая форма, при которой происходит некроз слизистой оболочки. Основные проявления: отказ от кормления, вздутие живота, кровянистый стул, общая слабость. Заболевание опасно для жизни и требует интенсивного наблюдения и специализированной терапии.
Диагностика
Диагностика энтероколита начинается с тщательного сбора анамнеза и осмотра пациента. Врач оценивает симптомы, характер диареи, боли в животе, наличие интоксикации и возможных факторов риска, таких как недавние инфекции или несоблюдение правил питания. Основное внимание уделяется длительности симптомов, частоте и консистенции стула, а также сопутствующим признакам: слабости, потере массы тела, повышенной температуре.
Диагностика энтероколита начинается с тщательного сбора анамнеза и осмотра пациента. Врач оценивает симптомы, характер диареи, боли в животе, наличие интоксикации и возможных факторов риска, таких как недавние инфекции или несоблюдение правил питания. Основное внимание уделяется длительности симптомов, частоте и консистенции стула, а также сопутствующим признакам: слабости, потере массы тела, повышенной температуре.
Для уточнения характера воспалительного процесса применяют инструментальные методы. Эндоскопия позволяет визуализировать слизистую тонкого и толстого кишечника, выявить очаги воспаления, эрозии, язвенные изменения и степень поражения. Биопсия тканей помогает определить морфологические особенности воспаления, исключить хронические патологии и дифференцировать инфекционные и аутоиммунные формы.
Лабораторные исследования включают общий анализ крови, который показывает признаки воспаления: лейкоцитоз, ускорение СОЭ, изменения количества лимфоцитов. Анализы кала помогают выявить патогенные микроорганизмы, их токсичность и дисбактериоз. В некоторых случаях назначают серологические тесты и ПЦР для обнаружения вирусов и бактерий. При тяжелых формах, таких как некротический энтероколит, необходим контроль электролитов, уровня белка и показателей свертываемости крови для оценки тяжести состояния.
Развитие заболевания
Энтероколит развивается по разным сценариям в зависимости от формы и причины. При остром энтероколите процесс начинается внезапно после попадания патогенных микроорганизмов в кишечник или раздражающих факторов. Сначала воспаляются слизистые оболочки тонкого кишечника, появляются боли, ускоряется перистальтика, нарушается всасывание жидкости, что вызывает диарею и обезвоживание. При дальнейшем распространении воспаление захватывает толстый кишечник, усиливаются боли и интоксикация организма.
Хронический энтероколит развивается постепенно. Воспалительный процесс сопровождается периодическими обострениями и ремиссиями. Со временем повреждение слизистой приводит к нарушению пищеварения и снижению всасывательной функции кишечника, что может вызвать дефицит витаминов и микроэлементов. У детей и новорожденных энтероколит развивается быстрее и сопровождается риском некротических изменений, особенно при ослабленном иммунитете или недоношенности.
Важной особенностью является способность заболевания переходить из острой формы в хроническую, если не устранены причины воспаления и не восстановлена нормальная микрофлора кишечника.
Осложнения
 Энтероколит кишечника может приводить к различным осложнениям, особенно при тяжелых или хронических формах. Одним из распространенных последствий является обезвоживание, вызванное диареей и нарушением всасывания жидкости. У детей и пожилых людей оно особенно опасно и может потребовать госпитализации.
Энтероколит кишечника может приводить к различным осложнениям, особенно при тяжелых или хронических формах. Одним из распространенных последствий является обезвоживание, вызванное диареей и нарушением всасывания жидкости. У детей и пожилых людей оно особенно опасно и может потребовать госпитализации.
Другие осложнения включают нарушение усвоения питательных веществ, что вызывает дефицит витаминов и минералов, истощение и снижение иммунитета. При длительном воспалении слизистой могут развиваться спайки, сужение кишечника и хронические боли. В редких случаях встречается некротический энтероколит, при котором части слизистой отмирают, что опасно для жизни и требует интенсивного наблюдения.
Лечение
Лечение энтероколита зависит от формы и причины заболевания. Основной целью терапии является устранение воспаления, восстановление функций кишечника и предотвращение осложнений.
При остром инфекционном энтероколите важны мероприятия по регидратации и восполнению электролитов, которые позволяют предотвратить обезвоживание. Наряду с этим применяют диетические рекомендации: мягкая пища, щадящий режим питания, ограничение раздражающих продуктов. В комплекс лечения входит нормализация работы кишечника и восстановление микрофлоры.
Хронические формы требуют длительного наблюдения. Основное внимание уделяется поддержанию нормального пищеварения, устранению воспаления и коррекции дисбактериоза. В некоторых случаях используется эндоскопическая терапия для оценки и лечения очагов воспаления, а также биопсия для контроля состояния слизистой. При некротическом энтероколите лечение направлено на предотвращение распространения некротических изменений, восстановление жидкости и электролитов, а также поддержание жизненно важных функций организма.
Важно, что терапия всегда комплексная и включает диету, контроль жидкости, наблюдение за лабораторными показателями, а при необходимости — инструментальные вмешательства.
Реабилитация
Реабилитация после энтероколита направлена на восстановление нормальной функции кишечника и предотвращение рецидивов. В этот период важно соблюдать диету с достаточным количеством клетчатки, витаминов и микроэлементов, постепенно расширяя рацион.
Особое внимание уделяется нормализации микрофлоры кишечника с помощью продуктов, богатых пробиотиками, и контролю водно-солевого баланса. Врач может рекомендовать регулярное наблюдение, повторные лабораторные исследования и контроль состояния слизистой кишечника, чтобы убедиться, что воспаление полностью прошло.
Для пациентов с хроническими формами реабилитация также включает корректировку образа жизни: уменьшение стрессов, соблюдение режима питания, профилактические меры против инфекций. Важным этапом является обучение пациента распознавать первые признаки обострения, что позволяет своевременно принимать меры и избегать осложнений.
Мнение эксперта
Своевременная диагностика и комплексный подход к лечению энтероколита позволяют остановить воспалительный процесс и восстановить нормальную функцию кишечника с минимальными осложнениями. Особенно важны корректировка питания, контроль водно-электролитного баланса, наблюдение за состоянием слизистой и поддержание микрофлоры кишечника.
Рекомендуется избегать самостоятельного назначения лекарственных средств и методов, которые не прошли клинических проверок, так как это может усилить воспаление, вызвать обезвоживание и ускорить развитие осложнений, таких как некротический энтероколит или переход в хроническую форму.
Профилактика
Профилактика энтероколита основана на соблюдении правил гигиены, правильном питании и укреплении иммунитета. Важно тщательно мыть овощи, фрукты и продукты животного происхождения, следить за свежестью пищи и качеством воды. При поездках в регионы с высоким риском кишечных инфекций рекомендуется соблюдать меры предосторожности и избегать употребления потенциально небезопасных продуктов.
Поддержание нормальной микрофлоры кишечника, регулярная физическая активность и своевременное лечение заболеваний ЖКТ уменьшают риск развития воспалительных процессов в тонком и толстом кишечнике. Для детей особое внимание уделяют профилактике вирусных и бактериальных инфекций, которые часто становятся триггером острого энтероколита.
Источники
Труханов В.В., Кузнецова И.А., Петров С.М. Энтероколит у взрослых и детей: современные подходы к диагностике и лечению. Журнал гастроэнтерологии и гепатологии, 2021;19(2):45-57.
Смирнова Т.П., Иванов А.В. Воспалительные заболевания кишечника: этиология, диагностика, терапия. Практическая медицина, 2020;14(4):102-110. Кожевникова Н.А., Лукина Е.С. Острый и хронический энтероколит: современные рекомендации. Современная педиатрия, 2022;25(1):33-42.
Коллектив авторов. Энтероколит у новорожденных: этиопатогенез и клинические формы. Российский журнал детских болезней, 2023;12(3):15-28.
Вопрос ответ
Как долго длится энтероколит?
Продолжительность энтероколита зависит от формы заболевания. Острый энтероколит обычно проходит в течение нескольких дней до двух недель при адекватной терапии и восстановлении баланса жидкости и электролитов. Хроническая форма может сохраняться месяцами и требовать длительного наблюдения и коррекции питания.
Чем отличается колит от энтероколита?
Колит — это воспаление толстого кишечника, тогда как энтероколит затрагивает одновременно тонкий и толстый кишечник, что сопровождается более выраженными нарушениями пищеварения, диареей и болями в животе.
Что нельзя есть при энтероколите?
При энтероколите следует избегать острых, жирных и жареных блюд, газированных напитков, алкоголя, продуктов с консервантами и слишком холодной или горячей пищи. Рекомендуется мягкая, легко усвояемая диета с ограничением раздражающих слизистую продуктов.


